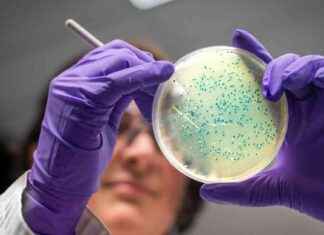
Salmonella Bacteria May Aid in Fighting Bowel Cancer, Study Finds news-19112024-070016

Tag: Salmonella research in cancer
Salmonella Bacteria May Aid in Fighting Bowel Cancer, Study Finds
Salmonella Bacteria Show Promise in Fighting Bowel CancerRecent research has shed light on a potential new treatment for bowel cancer involving the use of salmonella bacteria. While traditionally known for causing food poisoning, salmonella...